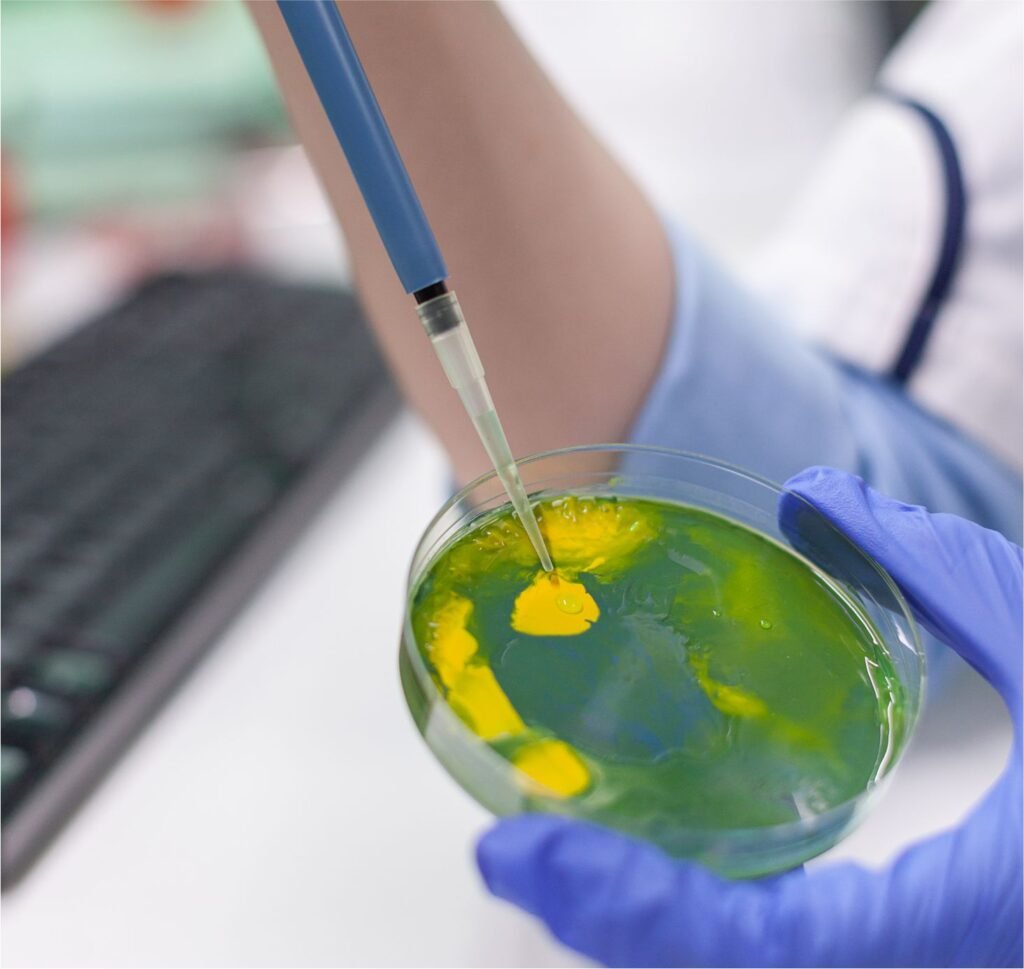

Cada produto passa por rigorosos processos científicos que garantem eficácia, pureza e sustentabilidade.
Desenvolvemos biopolímeros naturais de origem vegetal que atuam como espessantes e estabilizadores nas formulações, substituindo polímeros sintéticos por alternativas 100% biodegradáveis que criam texturas únicas.
Tecnologia que encapsula ativos naturais em nanopartículas, aumentando a penetração cutânea e eficácia dos ingredientes.





Transformamos a indústria através da união perfeita entre inovação tecnológica e respeito absoluto à natureza, provando que é possível criar formulações excepcionais com transparência total.
